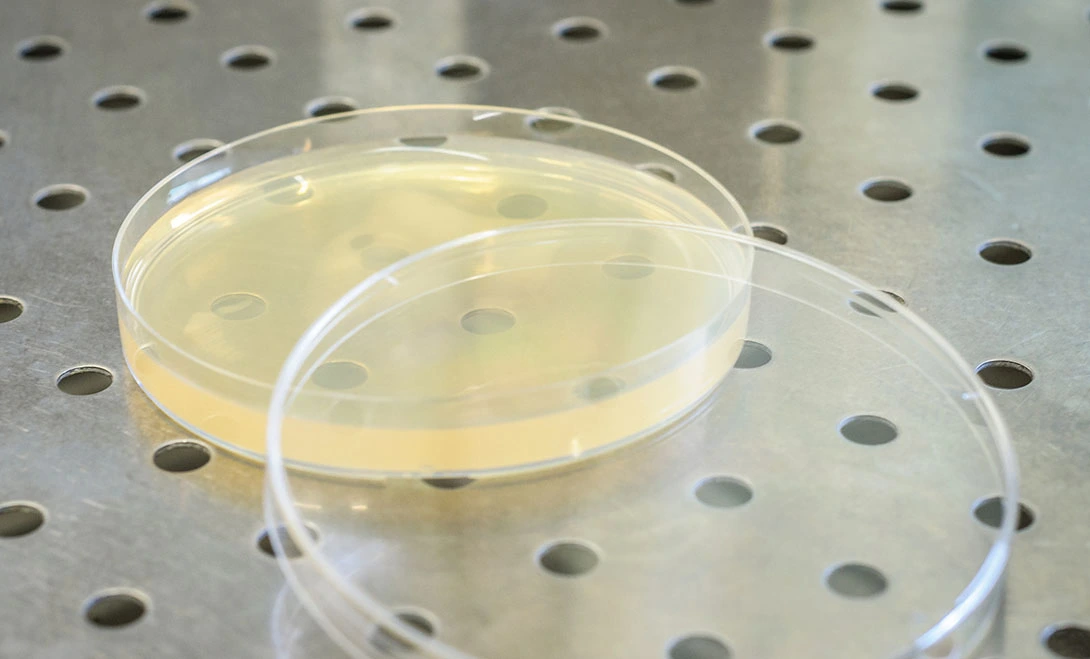
amino acid peptides amino acid peptides

When selecting Amino Acid Peptides for agricultural applications, the source of the peptides—plant-based or animal-based—plays a critical role in determining product performance, formulation stability, regulatory acceptance, and market potential. While both sources can supply essential nutrients for crop growth, differences in molecular structure, bioavailability, and sustainability significantly influence their suitability for modern agriculture. In recent years, yeast-derived peptides have emerged as an alternative that combines the advantages of plant and animal sources. This article examines the key differences among peptide sources to support informed formulation and marketing decisions.
Understanding Peptide Sources: Plant-Based vs Animal-Based
Plant-Based Amino Acid Peptides
lant-based Amino Acid Peptides are commonly derived from soybean meal, corn gluten, wheat protein, and other plant materials. Through enzymatic or chemical hydrolysis, large plant proteins are broken down into smaller peptides that plants can absorb. These sources are widely accepted due to their renewable nature and relatively favorable regulatory status, particularly in organic and sustainable farming systems.
However, plant-derived peptides often exhibit wide molecular-weight distributions and may lack certain functional amino acid sequences, limiting their performance in stress-response applications.
Animal-Based Amino Acid Peptides
Animal-derived peptides are typically produced from collagen, fish by-products, or other animal proteins. These peptides often contain specific amino acid sequences beneficial for cellular repair and structural support. Despite these functional advantages, animal-based peptides face increasing regulatory restrictions, environmental concerns, and limitations in organic certification, which reduce their acceptance in many international markets.
Yeast-Derived Peptides as an Alternative
Yeast-derived peptides represent a third category, produced through controlled fermentation and enzymatic hydrolysis. Using advanced processing, high-quality yeast proteins are converted into bioactive small-molecule peptides. Compared with animal-based sources, yeast peptides offer greater sustainability and regulatory flexibility, while delivering more complete amino acid profiles than many plant-based alternatives.
Bioavailability and Molecular Structure Differences
Molecular Weight and Absorption Efficiency
Bioavailability is closely linked to molecular size. Research indicates that peptides with molecular weights below 1000 Daltons exhibit the highest absorption efficiency in plants. Animal-derived peptides typically range from 500 to 2500 Da, while plant-derived peptides often extend from 800 to 3000 Da.
Advanced processing technologies, such as Full-Spectrum Directed Enzymatic Hydrolysis (FSDT), enable yeast-derived Amino Acid Peptides to achieve highly controlled molecular-weight distributions, with more than 80% of peptides ≤1000 Da. This precision enhances uptake speed and bioactivity under field conditions.
Key Absorption Factors
- Molecular size distribution: Smaller peptides penetrate plant cell walls more efficiently
- Amino acid composition: Balanced profiles support metabolic utilization
- Processing stability: Heat- and pH-resistant peptides maintain activity during application
Field evaluations suggest yeast-derived peptides are absorbed significantly faster than conventional plant-based peptides, supporting rapid physiological responses.

Stability and Compatibility in Agricultural Formulations
Formulation Stability
Formulation consistency is a major challenge in agrochemical development. Plant-based peptides may be sensitive to pH shifts and temperature fluctuations, while animal-based peptides can contain residual fats that interfere with spray systems.
Yeast-derived Amino Acid Peptides, produced through controlled fermentation and filtration, demonstrate superior formulation stability. Solutions remain homogeneous across a wide temperature range and show strong compatibility with fertilizers and crop protection products.
Practical Stability Advantages
- Temperature resilience from –5°C to 45°C
- Broad pH compatibility
- Chloride-free composition suitable for sensitive crops
- Extended shelf life with minimal bioactivity loss
Laboratory data indicate yeast-derived peptides retain a higher proportion of bioactivity during storage compared with conventional plant or animal alternatives.
Functional Benefits for Crop Performance
Beyond Basic Nutrition
In addition to nutrient supply, Amino Acid Peptides function as biostimulants, supporting stress resistance, yield stability, and crop quality. Plant-based peptides are effective for long-term nutritional support but may provide limited stress-response activation. Animal-based peptides can enhance cellular repair but face regulatory and application constraints.
Yeast-derived peptide formulations often combine multiple functional components, including:
- Signal peptides that activate plant defense mechanisms
- Nucleotides that support cellular repair and growth regulation
- Gluco-oligosaccharides that enhance nutrient uptake and root development
- Chelated micronutrients that improve nutrient efficiency
Field studies across multiple crops report yield improvements of 18–25% with yeast-based peptide formulations, compared with 8–12% from conventional plant-based products.
Market and Regulatory Considerations
Global Acceptance and Compliance
Regulatory requirements vary widely by region. Plant-based peptides are broadly accepted, while animal-based peptides face restrictions related to organic certification, religious compliance, and environmental impact. Yeast-derived Amino Acid Peptides occupy a favorable regulatory position, offering broad market access and flexibility.
Regional Market Preferences
- Southeast Asia: Preference for plant and yeast sources due to religious considerations
- Europe: Strict organic standards favor non-animal inputs
- Latin America: Emphasis on cost-efficiency and performance
- Middle East: Halal compliance limits animal-derived options
Market analyses suggest differentiated yeast-derived peptide products can achieve higher value positioning compared with generic plant-based alternatives.

Conclusion
The choice between plant-based and animal-based Amino Acid Peptides significantly influences product performance, formulation stability, regulatory acceptance, and market potential. Plant-derived peptides offer sustainability advantages, while animal-derived peptides provide specific functional benefits. However, yeast-derived peptides combine the strengths of both categories, delivering high bioavailability, strong stability, multifunctional performance, and broad regulatory acceptance.
Advanced yeast-based technologies, exemplified by controlled enzymatic hydrolysis processes, enable precise molecular design and consistent quality. For agricultural input companies seeking measurable performance improvements and global market compatibility, yeast-derived Amino Acid Peptides represent a forward-looking solution aligned with both agronomic and commercial objectives.
Partner with LYS for Premium Amino Acid Peptides Solutions
LYS leads agricultural innovation through advanced yeast-derived peptide technology that transforms crop performance and market positioning. Our AAPS biostimulant represents the next generation of functional raw materials, combining superior bioavailability with exceptional stability for demanding agricultural applications.
As a trusted amino acid peptides manufacturer with 70+ years of technical expertise, we provide comprehensive support for product development, formulation optimization, and market expansion. Our 10,000 MT annual production capacity ensures reliable supply chains for growing businesses worldwide.
Discover how our premium peptide solutions can enhance your product portfolio and strengthen market competitiveness. Connect with our technical team to discuss custom formulations and partnership opportunities - contact us at alice@aminoacidfertilizer.com.
References
1. Smith, J.K., et al. "Comparative Analysis of Plant and Animal-Derived Peptides in Agricultural Applications." Journal of Agricultural Biochemistry, 2023, 45(3), 234-251.
2. Rodriguez, M.A., and Thompson, L.R.. "Molecular Weight Distribution Effects on Peptide Bioavailability in Crop Systems." International Review of Plant Nutrition, 2022, 18(7), 445-462.
3. Chen, W.H., et al. "Yeast-Derived Bioactive Peptides: Processing Technologies and Agricultural Applications." Biotechnology in Agriculture and Food Production, 2023, 29(4), 178-195.
4. Anderson, K.L., and Martinez, P... "Regulatory Frameworks for Peptide-Based Biostimulants in Global Agricultural Markets." Agricultural Policy Review, 2022, 15(2), 89-106.
5. Williams, D.R., et al. "Economic Analysis of Peptide Sources in Commercial Fertilizer Formulations." Agribusiness Economics Quarterly, 2023, 31(1), 67-84.
6. Kumar, S.N., and Johnson, T.M.. "Stability and Compatibility of Amino Acid Peptides in Tank-Mix Applications." Crop Protection Science, 2022, 28(6), 312-329.
